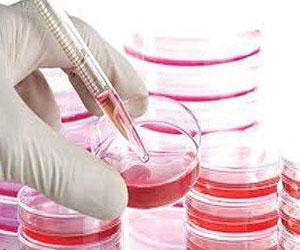
مصر اليوم - دراسة أسترالية تكشف عن مصدر جديد للخلايا الجذعية

الرئيسية
أخبارعاجلة
رياضة
- الأخبار الرياضية
- أخبار الرياضة
- فيديو أخبار الرياضة
- نجوم الملاعب
- اخبار الرياضة
- ملاعب مصرية
- بطولات
- أخبار الاندية المصرية
- مقابلات
- رياضة عربية
- رياضة عالمية
- موجب
- سالب
- مباريات ونتائج
- كرة الطائرة
- كرة اليد
- كرة السلة
- رمي
- قفز
- الجري
- تنس
- سيارات
- غولف
- سباق الخيل
- مصارعة
- جمباز
- أخبار المنتخبات
- تحقيقات
- مدونات
- أخبار المحترفين
ثقافة
إقتصاد
فن وموسيقى
أزياء
-
صحة وتغذية
-
سياحة وسفر
ديكور
دراسة أسترالية تكشف عن مصدر جديد للخلايا الجذعية
استراليا ـ يو بي أي
اكتشف باحثون أستراليون مصدراً جديداً للخلايا الجذعية وهو نسيج يتم التخلص منه عند الخضوع لجراحة استبدال الورك. وأفادت وكالة الأنباء الأسترالية (آيه آيه بي) اليوم الخميس ان بحثاً أسترالياً جديداً وجد ان هذا النسيج الذي يمكن الحصول عليه بعد جراحات استبدال الورك، يشكل مصدراً غنياً جداً بالخلايا الجذعية التي يمكن تخزينها بغية استخدامها لاحقاً. وقالت المعدة الرئيسية للدراسة البروفيسورة ميليسا كنوت تايت، ان هذه الخلايا يمكن ان تستخدم لزراعة عظام أو أنسجة جديدة بعد استئصال ورم أو التعرض لإصابة أو التهاب ما. وأضافت تايت ان عشرات آلاف جراحات استبدال الورك تجرى سنوياً، ما يوفر مصدراً كبيراً من الخلايا الجذعية. وأكد الباحثون ان هذه الخلايا حية ومفيدة بالرغم من انها لا تأتي من أطفال، بل من أشخاص يعانون من التهاب المفاصل.
GMT 08:40 2019 الأربعاء ,12 حزيران / يونيو
7 ملايين جنيه لتطوير وحدة الحضانات والغسيل الكلوي بمستشفى دكرنسGMT 01:55 2019 الأربعاء ,12 حزيران / يونيو
عادات خاطئة عند شراء البيض يُعرّضك للتلوثGMT 17:53 2019 الثلاثاء ,11 حزيران / يونيو
تفاصيل وفاة طبيبة داخل غرفة العمليات في مستشفى الساحل التعليمي في مصرGMT 17:35 2019 السبت ,08 حزيران / يونيو
معلومات مهمة عن واحد من أخطر أنواع السرطانGMT 18:23 2019 الخميس ,06 حزيران / يونيو
وزارة الصحة المصرية تُحذّر من 6 أدوية في الأسواقGMT 18:21 2019 الثلاثاء ,04 حزيران / يونيو
الصحة المصرية تحذر من عقار خطير بالأسواق لعلاج قرح المعدةGMT 09:27 2019 الثلاثاء ,04 حزيران / يونيو
سوء التغذية قد يزيد من خطر الإصابة بالسرطانGMT 22:03 2019 الإثنين ,03 حزيران / يونيو
"الصحة" تحذّر من عقار "جاست ريج" لعلاج اضطرابات المعدةمن أجل إنهاء اعتماد الاقتصاد على النفط وتوفير فرص عمل
السعودية تضاعف أصول "صندوق الاستثمارات" إلى تريليون ريال
الرياض - مصر اليوم
أعلن ولي العهد السعودي الأمير محمد بن سلمان، أن الحكومة السعودية تقوم حالياً بالعمل على إنهاء اتفاقيات خصخصة تتجاوز قيمتها ملياري ريال (533 مليون دولار) قبل نهاية العام الجاري. وتمثل حملة الخصخصة جزءاً من "رؤية ال...المزيدكشفت أن حسن الرداد ليس دكتاتورًا
ناهد السباعي ترفض قطعيًا أن تكون الزّوحة الثّانية
القاهرة - مصر اليوم
حسمتْ الفّنانة المصرية ناهد السباعي، موقفها من الزّواج بعد أزمة انفصالها، أواخر العام الماضي، مؤكّدة، أنّها ليست مستعدّة للارتباط في الوقت الحاليّ نهائيًا. وشدّدت السباعي، خلال استضافتها في أحد البرامج التلفزيو...المزيدتُحدّد مكانه ومدى تشوه السطح في غضون أيام
صور الأقمار الصناعية تساهم في رصد الزلازل
واشنطن - مصر اليوم
أكد باحثون في جامعة أيوا والمسح الجيولوجي الأميركي، أن البيانات التي يتم جمعها من الأقمار الصناعية المدارية يمكن أن توفر معلومات أكثر دقة عن تأثير الزلازل الكبيرة، والتي يمكن أن تساعد في توفير استجابة أكثر فعالية ...المزيدنظمها «فريق فكر للقراءة» في الأحساء
نوف نبيل وبوخمسين يُبدعان في أمسية شعرية
المنامة - مصر اليوم
شاركت الشاعرة البحرينية نوف نبيل والشاعر سلمان بوخمسين في الأمسية الشعرية التي نظمها «فريق فكر للقراءة» التابع لجمعية الثقافة والفنون بالأحساء ضمن البرنامج الثقافي الخميس الماضي. وذكرت المشرفة على فريق فكر...المزيدضمن مباريات المجموعة الثالثة لـ"كوبا أميركا"
غيابات نجوم الإكوادور يُسهّل فوز أوروجواي
واشنطن- مصر اليوم
All rights reserved 2026 Arabs Today Ltd.
All rights reserved 2026 Arabs Today Ltd.



























































أرسل تعليقك